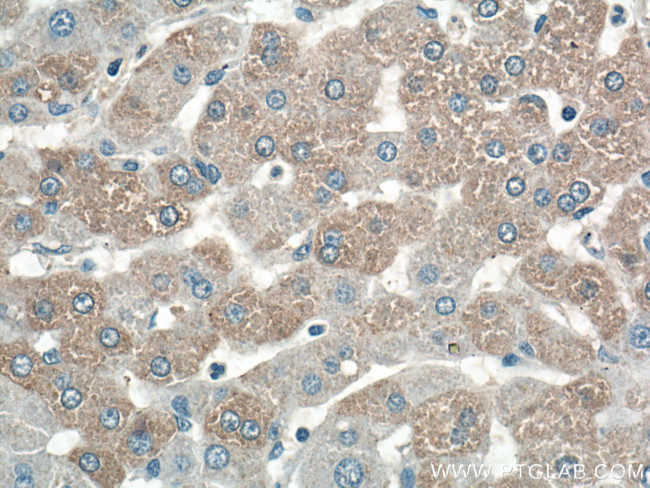
C7orf43 Antibody in Immunohistochemistry (Paraffin) (IHC (P))

Search
Proteintech
C7orf43 Polyclonal Antibody
{{$productOrderCtrl.translations['antibody.pdp.commerceCard.promotion.promotions']}}
{{$productOrderCtrl.translations['antibody.pdp.commerceCard.promotion.viewpromo']}}
{{$productOrderCtrl.translations['antibody.pdp.commerceCard.promotion.promocode']}}: {{promo.promoCode}} {{promo.promoTitle}} {{promo.promoDescription}}. {{$productOrderCtrl.translations['antibody.pdp.commerceCard.promotion.learnmore']}}
产品信息
27790-1-AP
种属反应
宿主/亚型
分类
类型
抗原
偶联物
形式
浓度
纯化类型
保存液
内含物
保存条件
运输条件
产品详细信息
The predicted MW of C7orf43 is 62 kDa. 27790-1-AP recognizes a 65-70 kDa band possibly due to phosphorylation.
Immunogen sequence: EHAQAGKQL CEEERRAMQA ALDSVVCHTP LNNLGFSRKG SALTFSVAFQ ALRTGLFELS QHMKLKLQFT ASVSHPPPEA RPLSRKSSPS SPAVRDLVER HQASLGRSQS FSHQQPSRSH LMRSGSVMER RAITPPVASP VGRPLYLPPD KAVLSLDKIA KRECKVLVVE PVK (409-580 aa encoded by BC015722)
靶标信息
Microtubule associated protein wich seems to play a role in spindle dynamics and cell division (PubMed:30715179, PubMed:30447097). Modulates YAP1 activity as transcriptional regulator (PubMed:30447097). [UniProt]
仅用于科研。不用于诊断过程。未经明确授权不得转售。
篇参考文献 (0)
生物信息学
蛋白别名: Microtubule-associated protein 11; Trafficking protein particle complex subunit 14; uncharacterized protein C7orf43 homolog
基因别名: C7orf43; MAP11; TRAPPC14
UniProt ID: (Human) Q8WVR3
Entrez Gene ID: (Human) 55262, (Rat) 288545